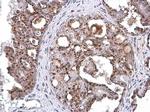
GOLPH2 Antibody in Immunohistochemistry (Paraffin) (IHC (P))

Search
Invitrogen
GOLPH2 Polyclonal Antibody
{{$productOrderCtrl.translations['antibody.pdp.commerceCard.promotion.promotions']}}
{{$productOrderCtrl.translations['antibody.pdp.commerceCard.promotion.viewpromo']}}
{{$productOrderCtrl.translations['antibody.pdp.commerceCard.promotion.promocode']}}: {{promo.promoCode}} {{promo.promoTitle}} {{promo.promoDescription}}. {{$productOrderCtrl.translations['antibody.pdp.commerceCard.promotion.learnmore']}}
图: 1 / 9
GOLPH2 Antibody (PA5-85235) in ICC/IF

产品信息
PA5-85235
种属反应
宿主/亚型
分类
类型
抗原
偶联物
形式
浓度
规格
纯化类型
保存液
内含物
保存条件
运输条件
RRID
产品详细信息
Keep as concentrated solution.
Positive Control: 293T, HeLa, HeLa membrane fraction, DU145.
Store product as a concentrated solution. Centrifuge briefly prior to opening the vial.
靶标信息
The Golgi complex plays a key role in the sorting and modification of proteins exported from the endoplasmic reticulum. The protein encoded by this gene is a type II Golgi transmembrane protein. It processes protein synthesized in the rough endoplasmic reticulum and assists in the transport of protein cargo through the Golgi apparatus. The expression of this encoded protein has been observed to be upregulated in response to viral infection.
⚠WARNING: This product can expose you to chemicals including mercury, which is known to the State of California to cause birth defects or other reproductive harm. For more information go to www.P65Warnings.ca.gov.
仅用于科研。不用于诊断过程。未经明确授权不得转售。
篇参考文献 (0)
生物信息学
蛋白别名: epididymis luminal protein 46; FLJ22634; FLJ23608; Golgi membrane protein 1; Golgi membrane protein GP73; Golgi phosphoprotein 2; golgi protein, 73-kD; GOLPH2; GOLPH2Ê; RP11-379P1.3; unnamed protein product
基因别名: bA379P1.3; C9orf155; GOLM1; GOLPH2; GP73; HEL46; PSEC0242; PSEC0257; UNQ686/PRO1326
UniProt ID: (Human) Q8NBJ4
Entrez Gene ID: (Human) 51280




